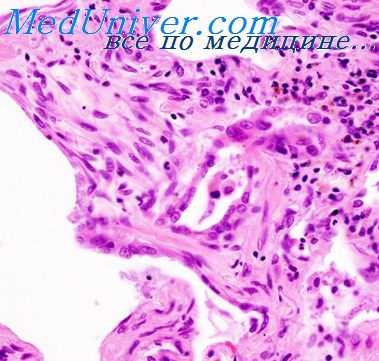
инородные тела альвеол

Стерильность альвеол. Инородные тела альвеол
Добавил пользователь Alex Обновлено: 27.12.2025
Стерильность альвеол. Инородные тела альвеол
Несомненно любопытно то, что и при обыкновенном ежедневном вдыхании бактерий альвеолы стерильны (Robertson 1942). Cralley (1942) давал кроликам вдыхать распыленную культуру Chromobacterium prodigiosum. При этом более чем 96 % задерживалось в верхних дыхательных путях. Из бактерий, которые попали в альвеолы, 90 % исчезало через 3 часа, а через 12 часов бактерии уже не были найдены в альвеолах, другие бактерии могут попасть туда в большом количестве (Nenninger 1901, Pal 1902, Quesnil 1902, Trillat 1923 и другие).
Неживые и живые частицы, попавшие в альвеолы, уже одним своим присутствием действуют как инородные тела, которые не могут оставаться незамеченными, тем более, если они действуют раздражающе своим химическим строением или освобождением химически действующих веществ или жизненной потребностью нуклеиновых кислот. Наряду с действием на капилляры, на размер их просвета и проницаемость стенки происходит активация, освобождение, и в зависимости от количества и вида раздражающего вещества может произойти пролиферация альвеолярных макрофагов.
Если проникают кремневые частицы, то происходит только эта реакция, а скопление многоядерных клеток, лимфоцитов, плазматических клеток или экссудативной жидкости не происходит. Зернышки кремневой пыли фагоцитируются и вначале повышают миграционную способность макрофагов. Токсические зернышки постепенно умерщвляют макрофаги (так, как это делают живые болезнетворные микробы).
Большинство макрофагов с фагоцитированными зернышками гранита, карборунда или битуминозного угля, однако, не проявляет такой активности, и эти зернышки не обладают такой предприимчивостью и способностью проникания; в большинстве они остаются в альвеолах (Gross 1926, Fenn 1921, Gardner 1932). Подобные различия реакций можно наблюдать и при воздействии живых вредных веществ.
Освобожденная после распада макрофагов кремневая пыль фагоцитируется дальнейшей серией или генерацией альвеолярных макрофагов. Пролиферация и миграция фагоцитов вызывают картину необыкновенной активности в альвеолярном очаге, картину реакции на кремневую пыль, которая отсутствует при других видах зернышек пыли (Gardner 1932).
Одновременно наблюдается явное стремление выделять фагоцитированные и нефаго-цитированные, свободные частицы по вентиляционным путям, которое бывает весьма успешным (Akazaki 1936, Gross 1926, 1953, Policard 1954, Вигдорчик 1954). При упомянутых реакциях могут разрастаться эпителиоидные элементы и возникают многоядерные гигантские клетки.
Только часть альвеолярного эпителия фагоцитирует, большая часть находится в состоянии покоя. Подобное состояние известно, например, при всасывании жиров из кишок. Во всасывании жира одновременно участвуют не все кишечные петли или их эпителий, значительная часть вполне отчетливо находится в состоянии покоя (Heubner 1896, Adam 1925). После внутритрахеального введения фагоцитируемого материала активные альвеолярные макрофаги наполняются им в течение нескольких минут (Seemann 1925).
Информация на сайте подлежит консультации лечащим врачом и не заменяет очной консультации с ним.
См. подробнее в пользовательском соглашении.
Нарушение дренажной функции лимфатической системы легких. Ретроградное течение лимфы в легких
Обычным важным последствием недостаточности дренажной деятельности лимфатических сосудов является уже упомянутый выше отек. Последствием хронического стаза лимфы являются фибротизирующие процессы, имеющие, с одной стороны, патогенетическое, с другой стороны, терапевтическое значение, например, при иммобилизации пневмотораксом. Послевоспалительный и послеателектатический фиброз развивается также вследствие нарушения дренажного свойства лимфатической системы, нарушения лимфатических сосудов в околодольковой, бронхомуральной и вазомуральной соединительной ткани.
Фиброзные изменения развиваются гилопетально и плевропетально от очага воспаления. При этом утолщаются и межальвеолярные перегородки (Kaufmann 1911, Штейн 1948, Есипова 1952, Foldi 1955, Hegglin 1956).
Наконец еще несколько слов о ретроградном течении лимфы в легких от гилюса к периферии. Ретоградное течение в лимфатических сосудах возможно, но при острых воспалительных болезнях оно не является ни патогенетически, ни регулярно встречающимся, ни необходимыми, ни, как правило, возможным способом распространения инфекции.
Большое количество анастомозов дает возможность преодолеть облитерированные части сосудов или непроходимые узлы.

Точно также и клапанные устройства преграждают ретроградное течение. При хронических пролиферативных, склеротизирующих или облитерирующих процессах ретроградное течение может быть частью патогенетических механизмов. При острых заболеваниях такие механизмы возможны, но не встречаются так часто, как предполагается (Стручков 1933, Рабинович 1935, Ротенберг 1949, Парфенова 1952, Foldi 1955, Rusznyak 1955). Если пневмонии возникают ретроградно лимфогенно, то возможно, что после закупорки соответственно большого лимфатического пути или узла мог бы возникнуть местный отек.
„Предпневмонический" отек действительно иногда удается установить, но его возникновение в конкретном случае всегда можно объяснять другими процессами, и без предположения блокады лимфатического пути остро засоренным узлом.
В заключение надо упомянуть, что и в системе лимфообращения легких может встречаться врожденный порок развития. Одной из таких форм является врожденное расширение лимфатических сосудов легких, что сопровождается серьезными нарушениями кровообращения (Maidman 1957).
Иногда после бронхографии удается томографически изобразить лимфатические сосуды. Через двадцать минут после бронхографии часть контрастного вещества (Иодурон Б) была обнаружена в перибронхиальных лимфатических сосудах, позже уже ничего не было найдено (Jahn 1957).
При застое лимфообращения и расширении лимфатических сосудов усиливается сосудистый и бронхиальный рисунок. В особенности у новорожденных лимфатические сосуды могут способствовать выразительности легочного рисунка.
Межклеточная проницаемость дыхательных путей. Отрицательное всасывательное давление вентиляционного цикла
Отделение активированных макрофагов, функциональная или патологическая ретракция цитоплазматических растяжений альвеолярных клеток образует в альвеолярных стенках пространства для паракапиллярного проникновения или пересасывания зернышек пыли в параальвеолярные щели и таким образом создает возможность для их дальнейшего периартериолярного, перибронхиолярного или перивенулярного передвижения по направлению к гилюсу.
Частицы пыли, если они достаточно малы, проходят свободно, возможно даже и через межклеточные щели, поры в спаивающей массе к базальной мембране альвеолярной выстилки. (Rake, 1937, доказал быстрое межклеточное прохождение через слизистую оболочку носа мышей пневмококков, Salmonella enteridis, вируса лошадиного энцефаломиэлита, прусской сини, и лишь медленное проникание вирусов бешенства и некоторых других вирусов.).
Через поры базальной пленки, непроходимой для макрофагов, они попадают в область течения тканевых соков, экстрацеллюлярной жидкости. Проникновение свободных зернышек пыли известно уже давно (Ziegler 1906, Akazaki 1936, Gross 1953, 1954). Оно наблюдалось в различных небольших, рассеянных по легким областях, часто из альвеол, лежащих вблизи бронхов и сосудов.
Проникание и распространение живых зернышек и живых неподвижных микробов в тканях происходит одинаковыми путями и одинаковым способом (Robertson 1941, Wilson 1948).

Важными физикальными факторами, которые дают возможность жидкостям и корпускулярным образованиям проникать через дыхательную мембрану и дальше передвигаться, является отрицательное всасывающее давление вентиляционного цикла, вентиляционные экскурсии легочной ткани и сотрясения от кашля. Внеальвеолярные области являются пространством с низким давлением, где последнее заметно ниже, чем в альвеолах.
Разница давления оказывает влияние на дренаж легочной ткани, на отток крови по венам, на отток лимфы по лимфатическим сосудам из области альвеол, а также и тканевых соков через пограничные мембраны альвеол и тканевые пространства и дальше в интерстициальную ткань. Ток жидкости направляется к перибронхиальным и периартериальным пространствам, что было описано уже многими авторами.
Частицы уносятся тканевой жидкостью по направлению к лимфатическим капиллярам или перибронхиальным, или периваскулярным очагам лимфоидной (лимфоретикулярной) ткани (Gardner 1932, 1933, 1934, Wulff 1934, Policard 1947, Gross 1926, Akazaki 1936), и это происходит без помощи фагоцитирующих клеток (Drinker 1933, 1945). Преодолеваемые относительные расстояния при этом не малые. Зернышко пыли размером в один микрон преодолевает в экстрацеллюлярных щелях расстояние в 1000 раз больше собственного размера, проходя вдоль одного миллиметра артериолы. Для частиц размером в 0,1, 0,5, 2,3 и до 10 микронов длина пути в 100 и 1000 и даже во много раз больше превосходит собственные размеры, когда они проходят вдоль альвеолярных ходов и респираторных бронхиол.
На своем пути вдоль артерий, бронхов, изредка вдоль вен, эти частицы проходят мимо некоторых фагоцитарных клеток или соприкасаются с ними и фагоцитируются ими. Свободные или освободившиеся после распада поврежденных макрофагов зернышки пыли ограничивают функцию перибронхиальных, периваскулярных, междольковых тканевых слоев, и, если не другим образом, то ограничением тока тканевых соков и лимфы вызывают местный стаз.
Аспирационная пневмония
Аспирационная пневмония – это инфекционно-токсическое повреждение легочной паренхимы, развивающееся вследствие попадания в нижние дыхательные пути содержимого ротовой полости, носоглотки, желудка. Аспирационная пневмония проявляется кашлем, тахипноэ, цианозом, тахикардией, болью в груди, лихорадкой, появлением зловонной мокроты. Диагностика аспирационной пневмонии опирается на аускультативные и рентгенологические данные, результаты бронхоскопии, микробиологического исследования содержимого нижних дыхательных путей и плеврального выпота. Лечение аспирационной пневмонии требует проведения оксигенотерапии, антибиотикотерапии, эндоскопической санации трахеобронхиального дерева; при необходимости проводится дренирование развившихся абсцессов или эмпиемы плевры.
МКБ-10
Общие сведения
Под аспирационной пневмонией в пульмонологии понимается воспаление легких, возникшее в результате установленного эпизода случайного попадания в нижние дыхательные пути содержимого ротоносоглотки или желудка. Среди различных форм пневмоний аспирационная пневмония имеет довольно большой удельный вес: на ее долю приходится около 23% случаев тяжелых форм легочной инфекции. Аспирационный синдром нередко встречается у практически здоровых лиц во время сна. Так, при исследованиях с ирригацией носоглотки раствором, меченным радиоактивными изотопами, аспирация была зафиксирована у 45-50% здоровых людей и у 70% пожилых пациентов в возрасте старше 75 лет с нарушением сознания.
Причины
Аспирационные пневмонии развиваются на фоне случайного попадания твердых частиц или жидкости в воздухоносные пути. Тем не менее, одного лишь факта аспирации недостаточно для возникновения аспирационной пневмонии. В механизме развитии пневмонии играет роль количество аспирированного содержимого и его характер, число микроорганизмов, попадающих в терминальные бронхиолы, их вирулентность, состояние защитных факторов организма.
В большинстве случаев этиология аспирационных пневмоний носит полимикробный характер. Более 50% случаев аспирационной пневмонии вызывается анаэробной флорой (бактероидами, превотеллой, фузобактериями, порфиромонадами, вейлонеллами и др.); около 10% - только аэробными видами (стафилококками, гемофильной палочкой, клебсиеллой, кишечной палочкой, энтеробактериями, протеем, синегнойной палочкой); в остальных случаях – комбинированной флорой. Важным микробиологическим субстратом при развитии аспирационной пневмонии выступает присутствие в ротовой полости и верхних дыхательных путях патогенной микрофлоры при кариесе, пародонтозе, гингивите, тонзиллите и т. д.
Факторы риска
Чаще всего преморбидным фоном для аспирационных пневмоний служат:
Нарушения сознания, обусловленные различными факторами:
- алкогольное опьянение
- общая анестезия
- передозировка лекарственных средств
Заболевания периферической и центральной нервной системы:
Заболевания, сопровождающиеся нарушением акта глотания (дисфагией) и регургитацией:
Травмы и ятрогенные повреждения:
- травматические и ятрогенные повреждения дыхательных путей при ранениях
- инородных телах трахеи и бронхов
- рвоте различного генеза
- проведении трахеостомии, интубации
- эндотрахеальных манипуляций.
В детском возрасте:
Патогенез
Сценарий развертывания событий при аспирации содержимого в трахеобронхиальное дерево может варьировать от полного отсутствия нарушений до развития респираторного дистресс-синдрома, дыхательной недостаточности и гибели пациента. Условиями, приводящими к развитию аспирационной пневмонии, служат нарушения факторов местной защиты в дыхательных путях и патологический характер аспирационных масс (количество, химические свойства и рН, степень инфицированности и пр.). Основными патогенетическими звеньями, приводящими к возникновению аспирационной пневмонии, выступают механическая обструкция дыхательных путей, острый химический пневмонит и бактериальная пневмония.
При вдыхании большого объема аспирата или крупных твердых частиц возникает механическая обструкция трахеобронхиального дерева. Возникающий при этом защитный кашлевой рефлекс способствует еще более глубокому проникновению аспирированного субстрата в бронхи и бронхиолы, что может привести к развитию отека легких. Механическая обструкция сопровождается развитием ателектазов легкого и застоем бронхиального секрета, на фоне которых увеличивается риск инфицирования легочной паренхимы.
В ответ на агрессивное воздействие аспирированного содержимого развивается острый химический пневмонит, характеризующийся выбросом биологически активных веществ, активацией системы комплемента, высвобождением факторов некроза опухолей, цитокинов и т. д. Дальнейшие патологические изменения в легочной паренхиме обусловлены ее повреждением биологически активными веществами, а не прямым действием аспирата. На фоне рефлекторного бронхоспазма, ателектаза части легкого, снижения легочной перфузии и прямого повреждения альвеол быстро развивается гипоксемия. С присоединением бактериального компонента нарастает дыхательная недостаточность, лихорадка, кашель, т. е. появляются все признаки бактериальной пневмонии. В этой стадии аспирационной пневмонии рентгенологически определяются очаги инфильтрации, нередко возникают легочные абсцессы и эмпиема плевры.
Симптомы аспирационной пневмонии
В клиническом течении аспирационная пневмония проходит этапы пневмонита, некротизирующей пневмонии, абсцедирования и эмпиемы плевры. В отличие от бактериальной легочной инфекции, клиника аспирационной пневмонии разворачивается постепенно и стерто. В течение нескольких дней после эпизода аспирации могут иметь место субфебрилитет, слабость, сухой мучительный кашель. В дальнейшем нарастают диспноэ, боли в грудной клетке, лихорадка, тахикардия, цианоз, выделение пенистой мокроты с примесью крови при кашле. Нередко, уже спустя 10-14 суток при аспирационной пневмонии возникает абсцедирование легочной ткани и эмпиема плевры. При этом появляется продуктивный кашель с выделением гнойной мокроты с гнилостным запахом, кровохарканье, ознобы.
Диагностика
На аспирационную пневмонию указывает наличие в анамнезе эпизода аспирации, подтверждаемое физикальными, рентгенологическими, эндоскопическими и микробиологическими данными. При осмотре выявляются признаки гипоксемии (одышка, цианоз, тахикардия), отставание пораженной стороны грудной клетки при дыхании, иногда - гнилостный запах изо рта. Для выяснения причин, приведших к аспирационной пневмонии, кроме осмотра пациента пульмонологом и торакальным хирургом, может потребоваться консультация гастроэнтеролога, невролога, отоларинголога.Подтверждающая диагностика включает:
- Рентген. Рентгенография легких в 2-х проекциях позволяет определить типичную локализацию аспирационной пневмонии в так называемых зависимых сегментах легкого: задних верхнедолевых и верхних нижнедолевых сегментах (при аспирации содержимого в горизонтальном положении) или нижних долях (при нахождении пациента во время аспирации в горизонтальной позиции). Кроме этого, определяются ателектазы легкого, очаги деструкции в легочной паренхиме, скопление газа над экссудатом в полости плевры.
- Выделение возбудителя. Важным этапом диагностики аспирационной пневмонии служит бактериологический посев мокроты на микрофлору с определением чувствительности к антибиотикам, а также бактериологическое исследование промывных вод бронхов. Поэтому с диагностической целью обычно прибегают к проведению бронхоскопии с забором мокроты, взятию промывных вод из трахеобронхиального дерева.
- Исследование крови. Для выяснения тяжести гипоксемии при аспирационной пневмонии исследуется газовый состав крови, КОС крови. Проводится исследование биохимических показателей крови, посев крови на стерильность, на аэробные и анаэробные бактерии.
Лечение аспирационной пневмонии
При аспирации инородных тел, приводящих к обтурации просвета воздухоносных путей, показано срочное эндоскопическое удаление инородного тела из трахеи/бронха. Проводится оксигенотерапия - подача увлажненного кислорода, в тяжелых случаях – интубация и ИВЛ. Основой лечения аспирационной пневмонии служит антибактериальная терапия. При назначении противомикробных препаратов учитывается чувствительность к ним анаэробных и аэробных возбудителей. При аспирационных пневмониях обычно назначают комбинации нескольких антибактериальных препаратов (например, фторхиналонов или цефалоспоринов и метронидазола). Продолжительность курса антибактериального лечения при аспирационной пневмонии составляет 14 дней.
При наличии абсцессов в легких выполняется их дренирование, проводится вибрационный массаж, перкуторный массаж грудной клетки. При необходимости осуществляется повторная трахеальная аспирация секрета, санационные бронхоскопии и бронхоальвеолярный лаваж. К хирургическому вмешательству прибегают при организации абсцессов больших размеров (более 6 см), легочном кровотечении, образовании бронхоплевральной фистулы. При аспирационной пневмонии, осложненной эмпиемой плевры, выполняется дренирование плевральной полости, проводятся санационные промывания, введение в полость плевры антибиотиков и фибринолитиков. Возможно проведение открытого дренирования (торакостомии), плеврэктомии с декортикацией легкого.
Прогноз и профилактика
При небольших объемах аспирированного содержимого, стабильном общем фоне и своевременном грамотном лечении, прогноз при аспирационной пневмонии не вызывает опасений. В случае развития массивного пневмонита, легочных абсцессов, эмпиемы плевры, бронхоплевральных свищей, сепсиса – прогноз крайне серьезен. Летальность при осложненном течении аспирационных пневмоний составляет 22%.
Учитывая высокий риск аспирационной пневмонии среди лиц, страдающих заболеваниями нервной и пищеварительной систем, необходимо проводить лечение основного патологического состояния. Пациентам с дисфагией и склонностью к аспирации рекомендуется дробное питание и щадящая диета. Для профилактики рефлюкса у пациентов с дисфагией, тяжелобольных и послеоперационных пациентов необходимо приподнимать головной конец кровати под углом 30-45°. Особое внимание следует уделять пациентам, находящимся на ИВЛ, зондовом питании. Большую роль в предупреждении аспирационных пневмоний играет гигиена и своевременная санация полости рта, регулярное посещение стоматолога.
2. Аспирационная пневмония: некоторые аспекты этиологии, патогенеза, диагностики и проблемы рациональной антибактериальной терапии/ Гайдуль К.В., Лещенко И.В., Муконин А.А.// Интенсивная терапия. - 2005 -№3.
Инородные тела легких и плевры
Инородные тела лёгких и плевры – посторонние предметы, находящиеся в альвеолярной ткани или плевральной полости и способные провоцировать развитие патологических состояний. Пребывание в лёгких мелких чужеродных предметов протекает бессимптомно. Средние и крупные инородные тела вызывают кашель с гнойной мокротой, лихорадку, кровохарканье. При локализации в полости плевры образуются плеврокожные свищи с гнойным отделяемым. Диагностика осуществляется на основании анамнеза, данных лучевых методов исследования органов грудной клетки, бронхоскопии. Патологические включения удаляются хирургическим путём.
Инородные тела лёгких, плевры обнаруживаются редко. Выявляемость посторонних предметов в грудной полости составляет 2-3% среди всех пациентов отделений торакальной хирургии с ранениями груди. Большинство пострадавших – взрослые мужчины. Мелкие (до 1 см) чужеродные металлические включения инкапсулируются и обычно не причиняют существенного вреда. Инородные предметы более крупных размеров вызывают нагноительные процессы в плевре и легких. Удалённые из лёгких осколки оказываются инфицированными в 70-98% случаев, пули – в 35-36%. Посторонние тела плевральной полости в меньшей степени обсеменяются патогенными микроорганизмами.
Инородные тела лёгочной паренхимы и плевры выявляются преимущественно во время военных действий, вооружённых конфликтов, террористических актов. Описываются немногочисленные случаи обнаружения подобных тел, не связанные с применением огнестрельного оружия. В зависимости от пути попадания в органы, ткани и полости дыхательной системы причины появления патологических включений подразделяются на:
- Огнестрельные ранения. Самым распространенным этиофактором внедрения чужеродных предметов в паренхиму лёгких и полость плевры являются слепые осколочные ранения. Пули реже застревают в тканях человеческого организма, нанесённые ими повреждения обычно бывают сквозными. Ещё реже встречаются вторичные инородные предметы (древесные щепки, обрывки одежды), попавшие в грудную полость с огнестрельным снарядом.
- Ятрогенные факторы. Инородные тела ятрогенного происхождения обычно обнаруживаются в плевральной полости через некоторое время после хирургических манипуляций в области грудной клетки. Это могут быть забытые в операционной ране марлевые салфетки, обломанные биопсийные щипцы, куски дренажных трубок, материал, ранее применявшийся для пломбирования туберкулёзных каверн.
- Неогнестрельные повреждения. Крайне редко при умышленном нанесении вреда человеку другим лицом в ткани лёгкого или полости плевры остаются обломки ножей, осколки стекла. Острые предметы (иглы) иногда преднамеренно с целью самоповреждения вводятся в полость груди чрезкожно пациентами с психическими заболеваниями. Инородные тела верхних дыхательных путей, пищевода могут стать причиной пролежня органа и мигрировать в лёгкие.
Реакция организма на внедрение чужеродного тела в альвеолярную ткань или плевру зависит от его размеров, свойств и локализации. Мелкие металлические частицы, расположенные удалённо по отношению к корням лёгких, подвергаются инкапсуляции. Образующаяся вокруг них соединительнотканная оболочка без нагноения отделяет такой предмет от здоровых тканей. При попадании в респираторный отдел более крупных тел не происходит полной облитерации раневого канала, кровоизлияние не рассасывается на протяжении нескольких месяцев. Формируется очаг хронического интерстициального воспаления. Течение пневмонии волнообразное, прогрессирующее с постепенным распространением процесса по ходу сосудистого русла и межальвеолярным перегородкам.
Отторжение неметаллических частиц почти всегда происходит через первичное нагноение. Присутствие чужеродного включения в паренхиме нередко становится причиной развития абсцесса или гангрены лёгкого. При дренировании пиогенной капсулы в просвет крупного бронха возможно самоудаление постороннего предмета через дыхательные пути и образование санированной каверны. Крупные (особенно ятрогенные неметаллические) инородные предметы плевры провоцируют развитие эмпиемы, чаще осумкованной с наличием плеврокожного свища.
Классификация
Инородные тела плевры, лёгких могут классифицироваться по причине попадания в дыхательную систему. По расположению в пульмональной ткани их подразделяют на посторонние включения кортикальной, срединной и прикорневых зон, плевральных сращений. Чужеродные объекты могут находиться в правом, левом или обоих отделах грудной клетки. Определённое клиническое значение имеет диаметр попавшей в плевру или лёгкое частицы. По размерам инородные предметы делятся на мелкие (менее 1 см), средние (1-2 см), крупные (более 2 см).
Симптомы инородных тел лёгких и плевры
Сразу после внедрения чужеродного предмета в лёгкое ощущается боль в груди по ходу раневого канала, рана кровоточит. Позднее инородные тела сравнительно небольших размеров могут ничем не проявлять своего присутствия на протяжении длительного (годы или десятилетия) промежутка времени. Толчком к распространению вялотекущего воспаления обычно служит снижение функций факторов иммунной защиты. У пациента появляются боли в грудной клетке, кашель. Отделяется гнойная жёлто-зелёная мокрота. Часто присоединяется кровохарканье, иногда развивается лёгочное кровотечение. Температура тела повышается до фебрильных значений.
Заболевание протекает по типу хронической пневмонии. Периоды ремиссии сменяются обострениями. Для каждого последующего эпизода характерны более тяжёлые проявления по сравнению с предыдущим обострением. Лихорадочный период длится дольше, кровохарканье присоединяется чаще и является более интенсивным. Нарастают одышка, симптомы общей интоксикации. Крупные инородные частицы не позволяют облитерироваться раневому каналу в течение двух и более месяцев. Боль в области раны ощущается в течение долгого времени, сопровождается клинической картиной нагноительного процесса в лёгких. Дренирование образовавшегося абсцесса в бронх сопровождается отхождением большого количества (полным ртом) мокроты с гнилостным запахом.
При нахождении постороннего предмета в плевре развивается хроническая, чаще осумкованная эмпиема. Возникают боли в груди на стороне поражения, эпизоды лихорадки с ознобами, малопродуктивный кашель, одышка при физической нагрузке. Заболевание постепенно прогрессирует. Развивается хроническая дыхательная недостаточность. Кашель становится постоянным, одышка появляется в покое. Больной ощущает выраженную слабость, утомляемость. Аппетит снижается, пациент заметно худеет, грудная клетка деформируется. Для эмпиемы характерно наличие плеврокожных свищей.
Осложнения
К ранним осложнениям слепых ранений относят пневмоторакс, гемоторакс, ателектаз сегмента, доли или лёгкого. Позднее неудалённые тела средних и крупных размеров всегда вызывают хроническое воспаление или нагноение, могут потенцировать абсцедирование лёгкого либо его гангрену. Инородные частицы плевры провоцируют возникновение эмпиемы, очень редко являются фоном для появления новообразования. Длительно текущий патологический процесс приводит к дыхательной недостаточности и лёгочному сердцу. Присутствие посторонних частиц в респираторных органах нередко осложняется лёгочными кровотечениями, формированием бронхоэктазов.
Инородные включения лёгких, плевры диагностируются торакальными хирургами. Правильно собранный анамнез позволяет уточнить наличие и характер травм грудной клетки, выяснить, проводились ли хирургические вмешательства в этой области. При осмотре выявляются изменения, характерные для хронически текущего воспалительного процесса органов дыхания. В запущенных случаях присутствует цианоз кожных покровов, наблюдается деформация грудной клетки, отставание её половины во время дыхания, утолщение концевых фаланг пальцев рук по типу барабанных палочек, изменения ногтей по типу часовых стёкол, обнаруживаются плеврокожные свищи. Окончательный диагноз устанавливается с помощью:
- Физикальных данных. Патогномоничные признаки наличия инородного тела в лёгком или плевре отсутствуют. Физикальные исследования помогают выявить обострение хронического гнойно-воспалительного процесса. При лёгочной локализации постороннего предмета выслушиваются сухие и разнокалиберные влажные хрипы. Дыхание при эмпиеме плевры резко ослаблено или не проводится в нижние отделы соответствующей половины грудной клетки.
- Лучевых исследований лёгких. Являются основными методами диагностики. На рентгенограммах и КТ лёгких просматриваются рентгенконтрастные инородные тела, заключённые в полость, окружённые зоной перифокального воспаления либо пневмосклероза. Бронхография позволяет обнаружить деформацию бронхов и вторичные бронхоэктазы. Наличие неконтрастных частиц выявляется с помощью плеврографии, фистулографии.
- Бронхоскопии. Относится к дополнительным методам исследования. Редко, при локализации патологического тела вблизи крупного бронха, появляется возможность эндоскопически визуализировать его поверхность и удалить включение с помощью щипцов. Чаще при бронхоскопическом исследовании определяется присутствие гноя, примеси крови в дренирующем бронхе.
С целью обнаружения маркёров воспаления диагностические мероприятия дополняют лабораторными анализами. Для уточнения степени дыхательной или лёгочно-сердечной недостаточности осуществляют определение насыщения крови кислородом, исследование функции внешнего дыхания, электрокардиография. При необходимости назначают консультации пульмонолога, кардиолога, фтизиатра, онколога. В неясных случаях выполняют видеоторакоскопию.
Лечение инородных тел лёгких и плевры
Чужеродные тела подлежат обязательному удалению во время первичной обработки раны. Если такая обработка не выполнялась, последующая тактика ведения пациента зависит от месторасположения и размера предмета. Мелкие инкапсулированные частицы, не причиняющие вреда больному, рекомендуется не удалять из-за высокого риска развития интра- и послеоперационных осложнений. Крупные предметы любой локализации, а также средние, поддерживающие воспалительный процесс или расположенные вблизи корней лёгких, магистральных сосудов подлежат извлечению.
Предпочтение отдаётся малоинвазивным оперативным вмешательствам. Чужеродные тела плевры или локализованные субплеврально, удаляются видеоторакоскопическим доступом. Предметы, расположенные рядом с крупными бронхами, иногда можно извлечь при проведении фибробронхоскопии. В остальных случаях выполняется торакотомия. При сопутствующих нагноительных процессах, бронхоэктазиях осуществляется экономная резекция лёгкого на фоне антибактериальной терапии. В послеоперационном периоде продолжается лечение антибиотиками, назначаются физиотерапевтические процедуры, лечебная физкультура.
Прогноз при своевременном удалении постороннего тела благоприятный. Наступает полное выздоровление и восстановление трудоспособности. Хронизация нагноительного процесса приводит к формированию респираторно-сердечной недостаточности и инвалидизации пациента. К первичным превентивным мерам относится осторожное общение с оружием и колюще-режущими предметами, профилактика ятрогении. Удаление инородного тела при первичной хирургической обработке раны является вторичным профилактическим мероприятием.
1. Инородные тела грудной клетки: диагностика и хирургическое лечение/ Колос А.И., Джиешев Ж.А., Айтбаева А.К., Герасимова М.В.// Клиническая медицина Казахстана. – 2015 - №4.
4. Foreign Bodies in Pleura and Chest Wall/ Dov Weissberg, Dorit Weissberg-Kasav// The Annals Of Thoracic Surgery – 2008 – Т.86, №3.
Читайте также:
